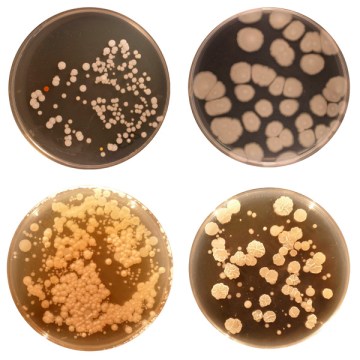
bacteria of the belly button

Photo Credit: Neil McCoy
A recent study published in PLOS ONE has guided us to a greater knowledge of which bacteria are commonly found in belly buttons. The Smithsonian article on the study sums it up pretty well, saying:
A team of researchers dug into 60 different people’s belly buttons and turned up bacterial diversity and microbial mystery. All in all, they identified more than 2,000 species of bacteria as well as two species of archaea, the ancient predecessors of bacteria. Some of the species frequently occurred in multiple belly buttons, while others were confined to just a few participants.
Microbe World, a website dedicated to promoting awareness and understanding of key microbiological issues, gives a little insight as to where archaea are normally found stating that:
Archaea comes from the Greek word meaning “ancient.” An appropriate name, because many archaea thrive in conditions mimicking those found more than 3.5 billion years ago. Back then, the earth was still covered by oceans that regularly reached the boiling point — an extreme condition not unlike the hydrothermal vents and sulfuric waters where archaea are found today.
Some scientists consider archaea living fossils that may provide hints about what the earliest life forms on Earth were like, and how life evolved on our planet.
So, various bacteria, including previously unknown bacteria, and two archaea were found in a small range of North American belly buttons. But the researchers aren’t finished yet. In a guest blog on Scientific American, Rob Dunn, the study’s lead author, talks of a future research plan saying:
Instead of the 66 samples we included in our first paper, or the 300 we have now, we will soon have over 600 samples of people processed, people from all over North America. With this variety, we may well begin to explain the differences among people in terms of the intimate forests of their umbilicus. On the other hand, we may still be unable to account for our differences; it may be that part of what determines who lives on you is stochastic, a fancy scientific word for what happens when fate and the universe’s contingencies come together in your navel.
Carl Zimmer, another scientist working with the project talks of his results in a blog post on the Discover website. He had a very diverse spread of bacteria in his belly button and 17 bacteria that were not found in any of the other subjects.
I know that diversity can make ecosystems work better. One of the most important services that our microbial ecosystem performs for us is protecting us from pathogens. They can outcompete invaders, kill them with poisons, and otherwise ward them off. Scientists have run experiments to test the effect of diversity on infections. They manipulated mice so that some had no resident bacteria, and others had low levels of diversity. The researchers found that pathogens did a better job of invading low-diversity mice than high-diversity ones.
Several of the bacteria found in people’s navels had never been found on humans before and Zimmer discusses some of the bacteria found in his navel in his blog post saying:
Several species I’ve got, such as Marimonas, have only been found in the ocean before. I am particular baffled that I carry a species called Georgenia. Before me, scientists had only found it living in the soil.
In Japan.
Belly buttons aren’t the only place where thriving biomes are being discovered. Scientists have discovered a mobile ecosystem that lives in freezing temperatures. The world is so intriguing! Life is everywhere!
Sources and Extra Reading for the Curious:
PLOS ONE- A Jungle in There: Bacteria in Belly Buttons are Highly Diverse, but Predictable
The Smithsonian- A Flourishing Microbial Community Dwells Within Your Belly Button
Discover- Discovering my microbiome: “You, my friend, are a wonderland”
Wondergressive- The Secret World of Bacteria
Wondergressive- New Ecosystem Discovered: Glacier Mice
Wondergressive- Life, It’s All Over the Place
Wondergressive- 2800 Year Old Lake Life Survives in Complete Isolation



